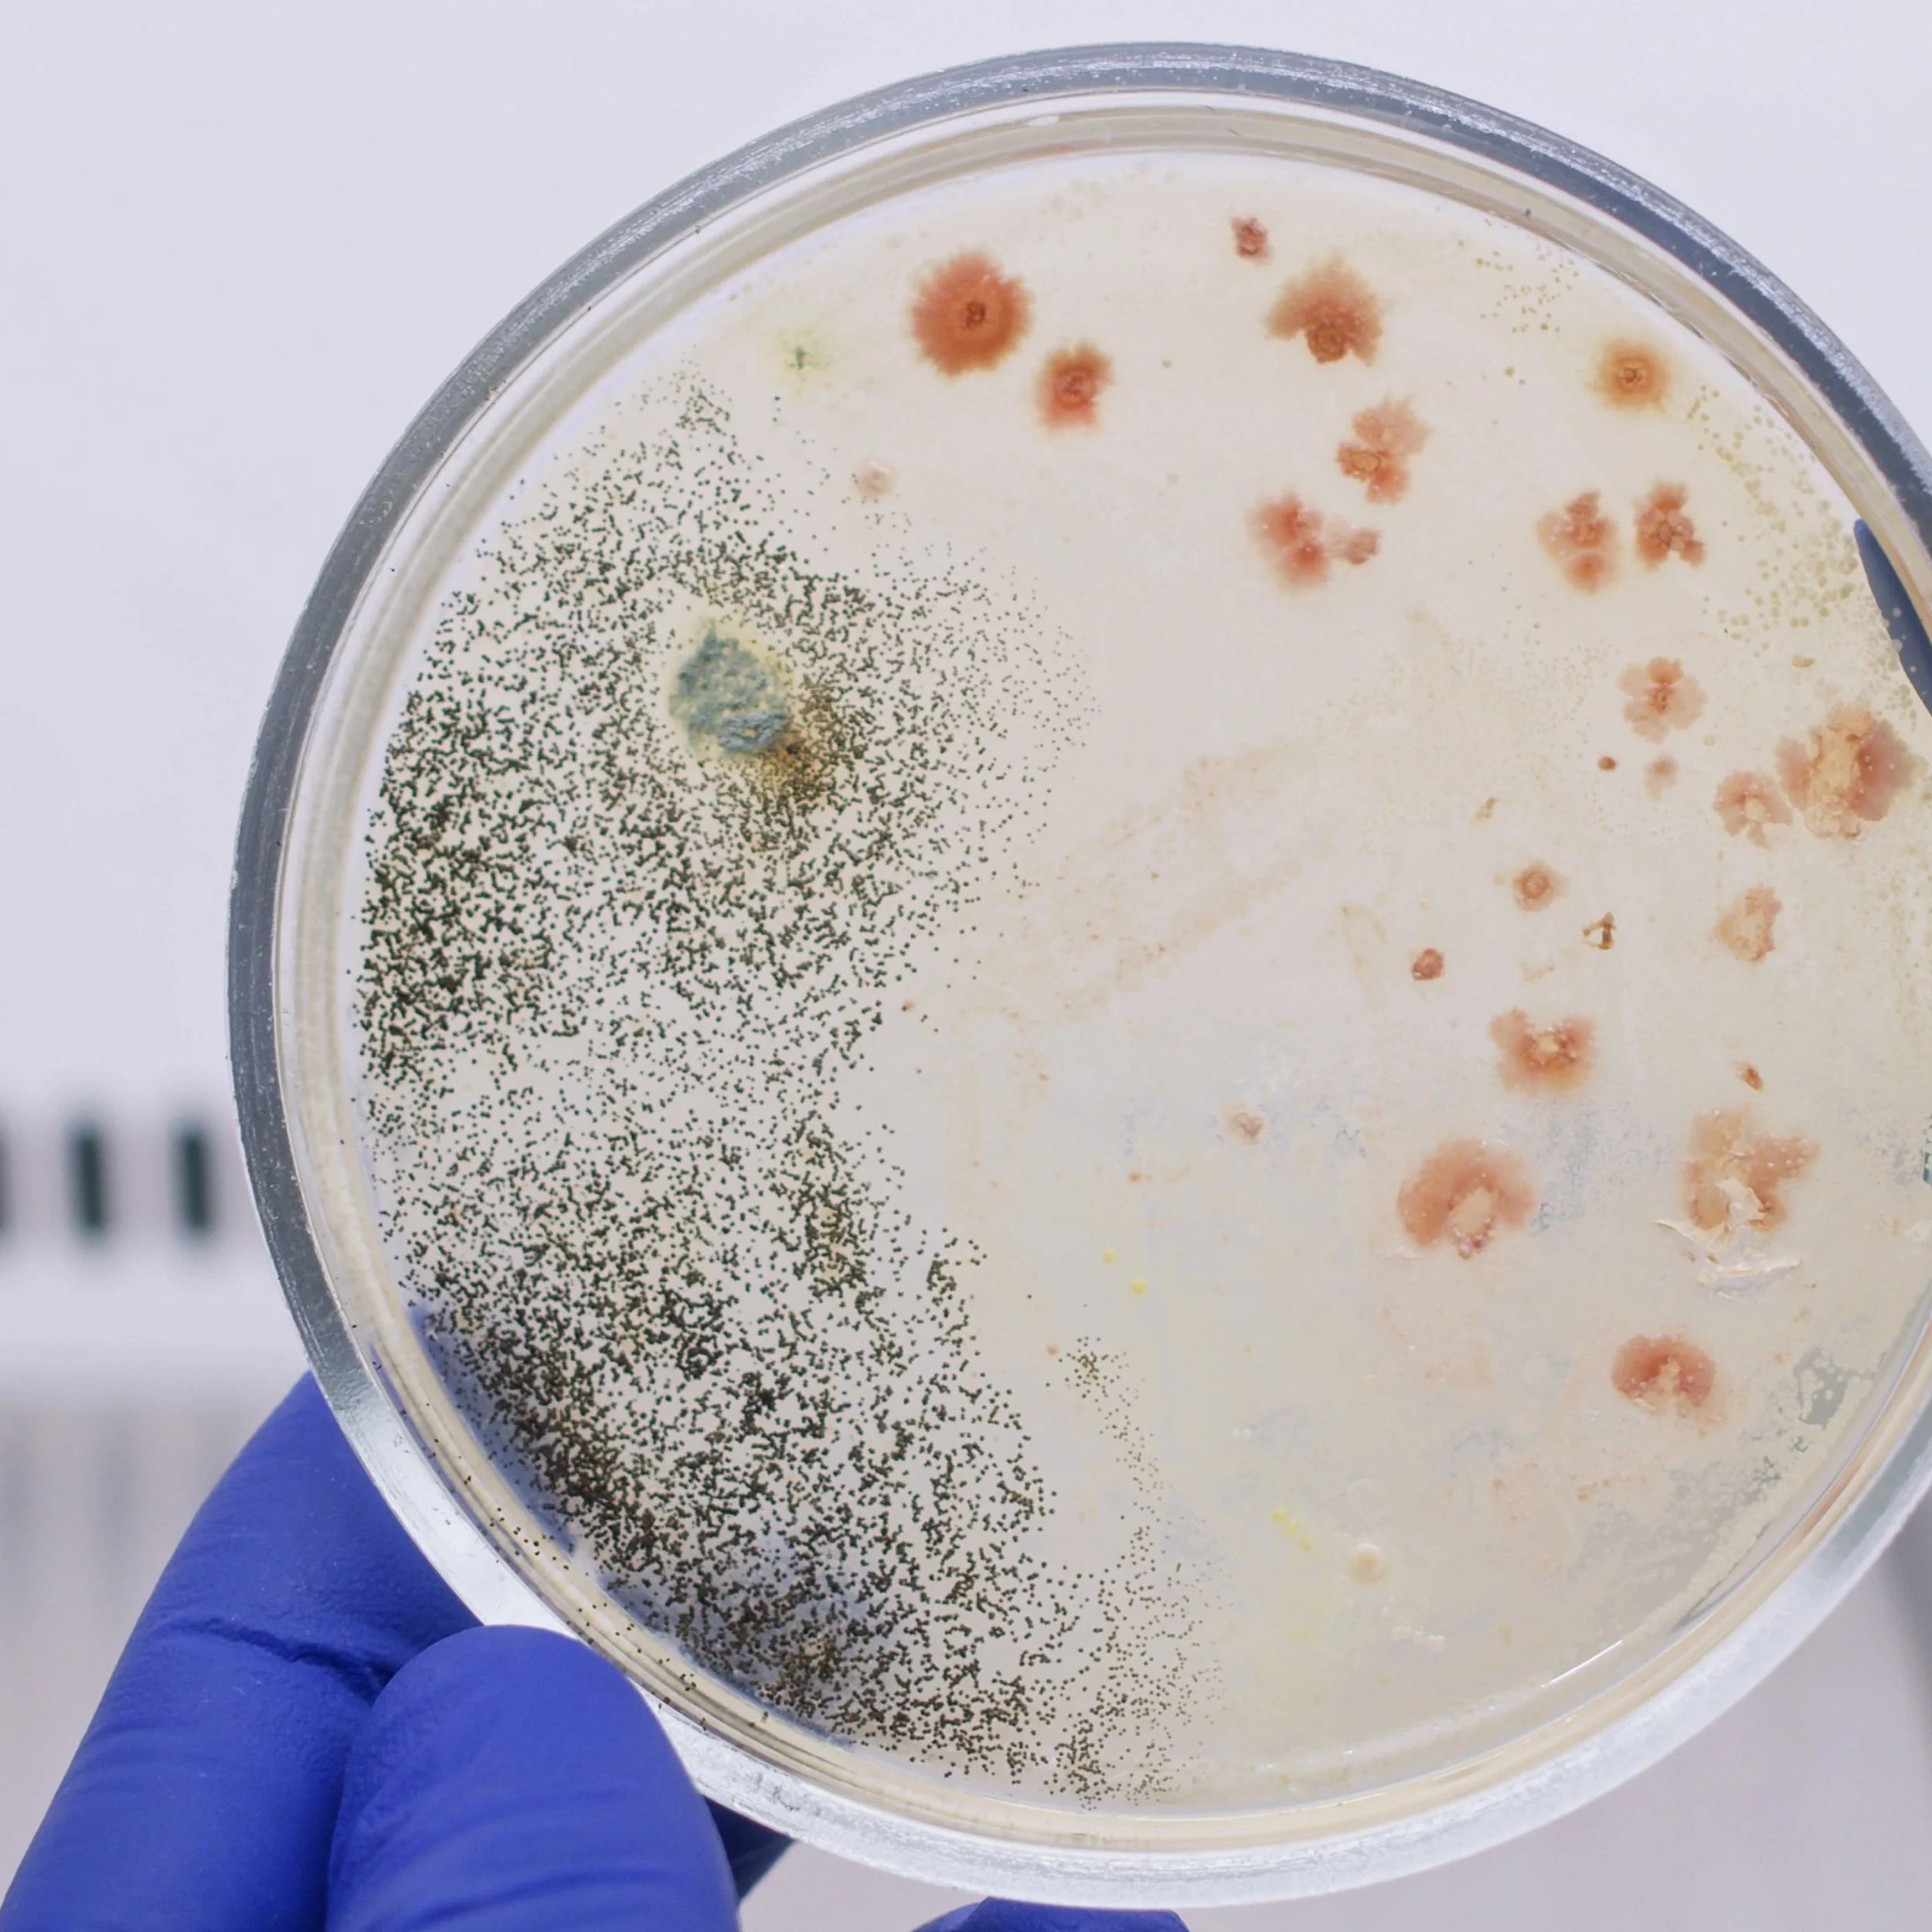
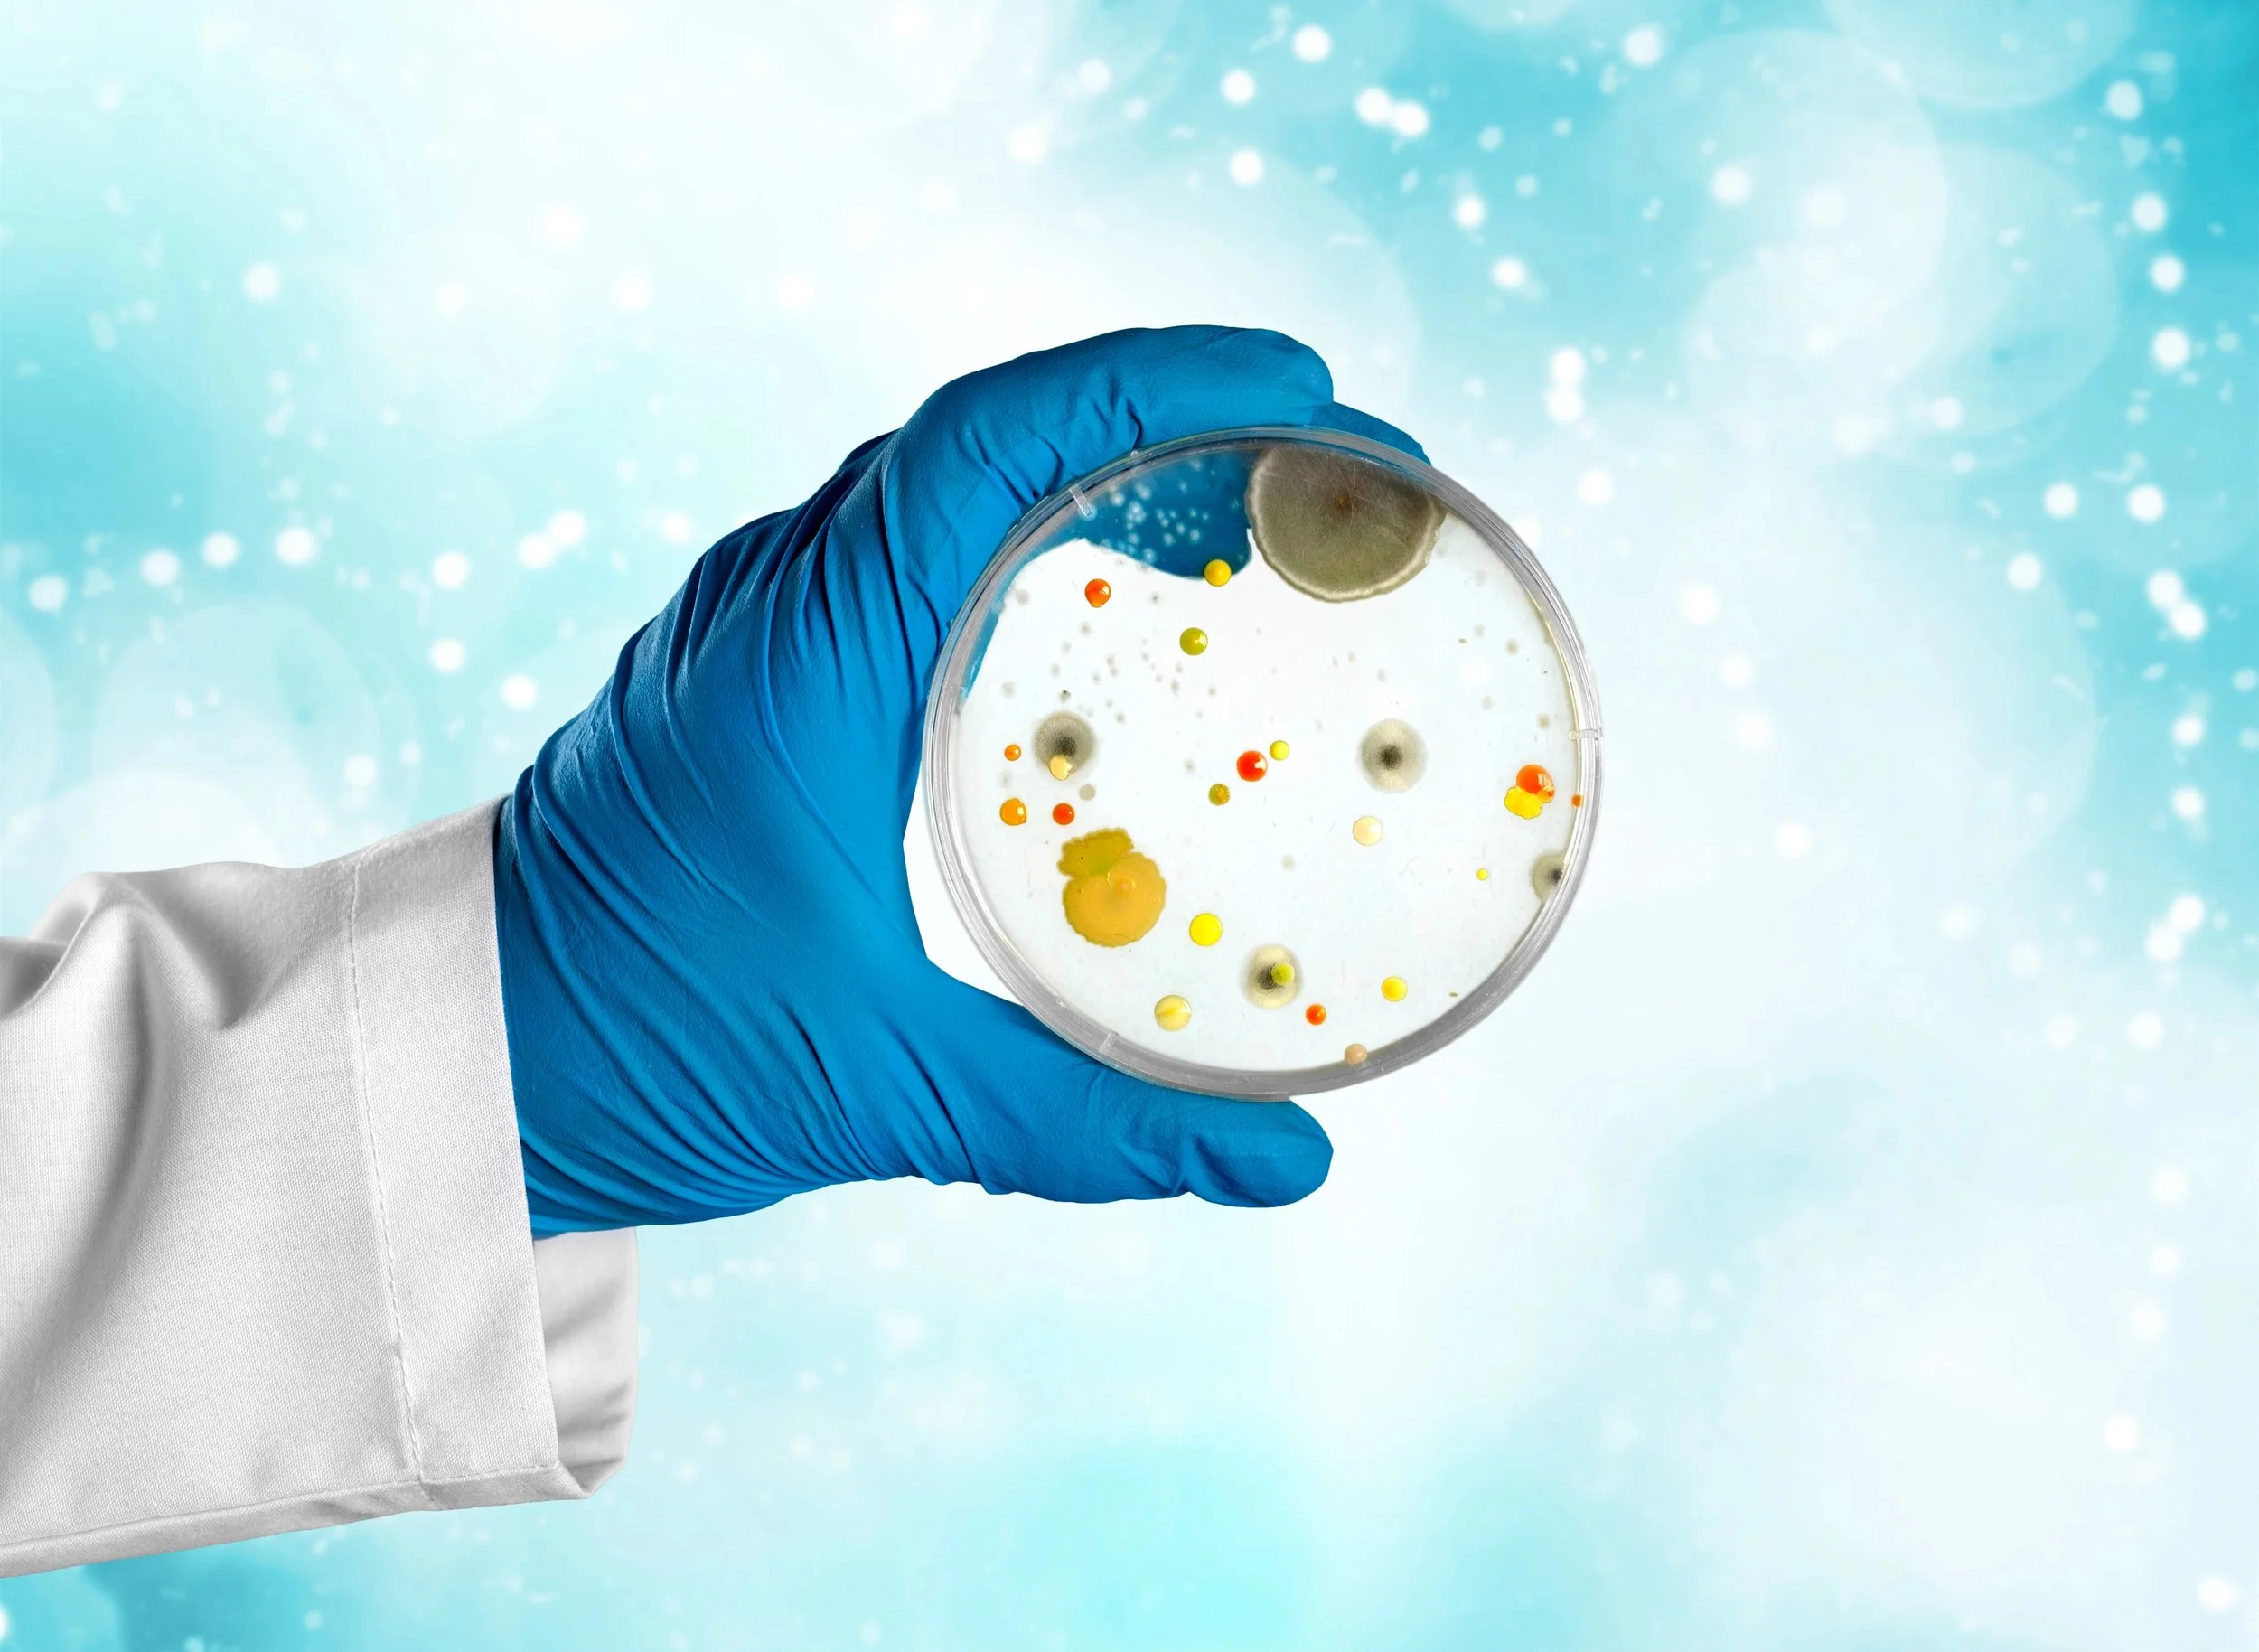

Marketing for Mold Testing & Remediation Companies
Clean Up Your Lead Flow
Be the first call when mold strikes. TruLata’s SEO, Google Ads, web design, and automation services help mold testing and remediation companies capture urgent leads and high-value jobs before the competition.
Challenges in Mold Testing & Remediation
⏱ Emergency-driven demand – Whether it’s testing for black mold or scheduling full remediation, customers want answers immediately. If you’re not visible online at that moment, competitors win the job.
💸 High lead costs – Mold-related keywords are among the most expensive in home services. Without precise targeting, ad spend disappears quickly.
🛡 Trust and health concerns – Mold impacts health and property value. If your website doesn’t highlight certifications, clear testing processes, and proof of past work, homeowners choose a more “professional-looking” competitor.
📉 Seasonal slowdowns – Inquiries spike after storms or during humid seasons but drop in between. Without a strategy, revenue becomes unpredictable.

How TruLata Helps Testing & Remediation Companies
We position your business as the go-to local expert for mold removal and testing. From emergency search ads to credibility-focused websites, we capture leads at the moment they’re ready to hire. Our system also smooths seasonality by nurturing past clients and property managers for repeat business. With TruLata, you’ll stop relying on referrals or overpriced lead brokers and instead build a steady pipeline of direct, exclusive leads that convert into high-value jobs.
Marketing Services for Mold Testing & Remediation
🌐 SEO Domination
Rank for critical searches like “mold testing near me,” “black mold inspection,” and “mold remediation services.” We optimize service pages, blogs, and your Google Business Profile to make you the obvious choice.
🎯 Google Ads Campaigns
Target commercial-intent searches such as “mold inspection cost” or “emergency mold removal.” We block wasteful clicks from DIYers and info-seekers, focusing budget only on qualified leads ready to hire.
💻 Conversion-Focused Websites
Fast, mobile-first websites with separate service pages for mold testing and mold remediation. We feature certifications, process explanations, before/after galleries, testimonials, and clear calls-to-action like “Schedule a Mold Test Today.”
📲 CRM & Lead Response Automation
Every testing or remediation inquiry enters a CRM and triggers instant alerts. Automated texts and emails confirm you’ve received their request and reassure them while you prepare a fast response.
⭐ Reputation & Reviews
Reviews mentioning “accurate testing” and “thorough remediation” build trust. We automate review requests and showcase credentials (like IICRC) to prove your expertise in both services.
Results You Can Expect
Mold remediation clients often see dramatic results within weeks. One contractor went from a handful of calls each month to multiple inquiries daily after TruLata optimized their SEO and Google Ads.
“We used to rely on insurance referrals and word of mouth. Now, people find us directly on Google and call immediately. We’re booking more jobs than ever and even hired extra techs to keep up.”
Ready to Capture Every Mold Lead?
When homeowners discover mold, they want it gone now. The companies they see first online get the calls – and the revenue.
TruLata helps you:
🏆 Dominate local search rankings.
📞 Turn emergency searches into phone calls.
🚀 Convert website visitors into booked inspections.
🔄 Smooth out seasonal dips with automation and retention.
Mold remediation jobs are high-value – sometimes $2,000 to $10,000 or more. With the right system, a single new client can cover months of marketing spend.
👉 Schedule your free consultation today and see how TruLata can deliver more leads, more jobs, and more revenue for your mold remediation business.